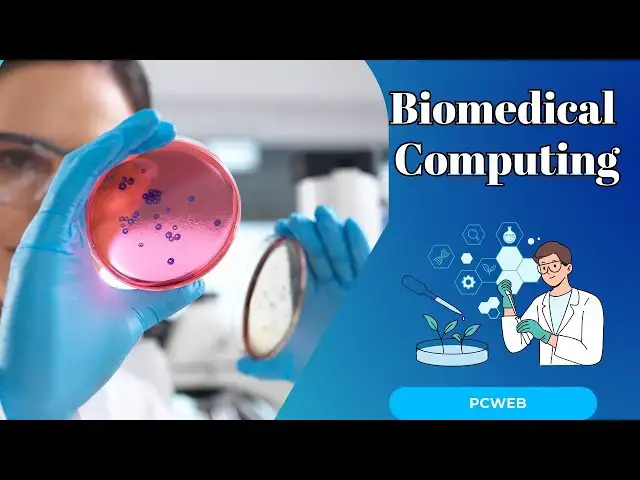
Video thumbnail for Biomedical Computing:Revolutionizing Healthcare Through Technology

Biomedical Computing:Revolutionizing Healthcare Through Technology
Aug 19, 2024
Biomedical Computing: Revolutionizing Healthcare Through Technology
In a world where technology evolves at lightning speed, biomedical computing stands at the forefront of healthcare innovation. Imagine a future where diseases are detected early, treatments are personalized, and medical procedures are minimally invasive. This is not science fiction but the reality being shaped by biomedical computing.
Biomedical computing is an interdisciplinary field combining computer science, biology, and medicine to develop technologies that improve healthcare outcomes. It leverages computational tools to analyze biological data, model biological processes, and create advanced medical devices. This fusion of technology and biology holds the promise of transforming how we understand and treat medical conditions.
The value proposition of biomedical computing is clear: it enhances the precision, efficiency, and effectiveness of medical interventions. By utilizing computational models, healthcare professionals can simulate and predict the progression of diseases, leading to more accurate diagnoses and tailored treatment plans. For instance, in oncology, biomedical computing enables the analysis of genetic data to identify specific mutations driving cancer, allowing for the development of targeted therapies that increase survival rates and reduce side effects.
Furthermore, biomedical computing plays a crucial role in the development of wearable health devices. These devices, equipped with sensors and advanced algorithms, continuously monitor vital signs and provide real-time feedback. This constant stream of data can alert individuals to potential health issues before they become critical, facilitating early intervention and improving overall health management.
One of the most significant contributions of biomedical computing is in the realm of medical imaging. Techniques such as MRI, CT scans, and ultrasounds have become indispensable tools in modern medicine. Biomedical computing enhances these imaging technologies by improving image resolution, enabling 3D visualization, and integrating artificial intelligence to assist in image interpretation. This leads to more accurate diagnoses and better patient outcomes.
Moreover, biomedical computing is driving advancements in robotic surgery. Robotic systems, guided by sophisticated algorithms, allow surgeons to perform complex procedures with greater precision and control. This minimizes the risk of complications, reduces recovery times, and improves surgical outcomes.
To harness the full potential of biomedical computing, ongoing research and collaboration among computer scientists, biologists, and medical professionals are essential. The integration of artificial intelligence, machine learning, and big data analytics continues to open new frontiers in personalized medicine, predictive analytics, and healthcare automation.
As technology and medicine converge, the future of healthcare looks brighter than ever. Biomedical computing not only promises to revolutionize medical practice but also empowers individuals to take control of their health through innovative solutions. Are you ready to embrace the future of healthcare and explore the limitless possibilities of biomedical computing?
See more:
Understanding the Function of Folic Acid: A Vital Nutrient for Health
https://youtu.be/XI60MTp2z-8
#BiomedicalInnovation #HealthTechRevolution #FutureOfHealthcare
Show More Show Less #Pharmaceuticals & Biotech
#Computers & Electronics
#Medical Devices & Equipment
#Medical Facilities & Services
#Robotics

